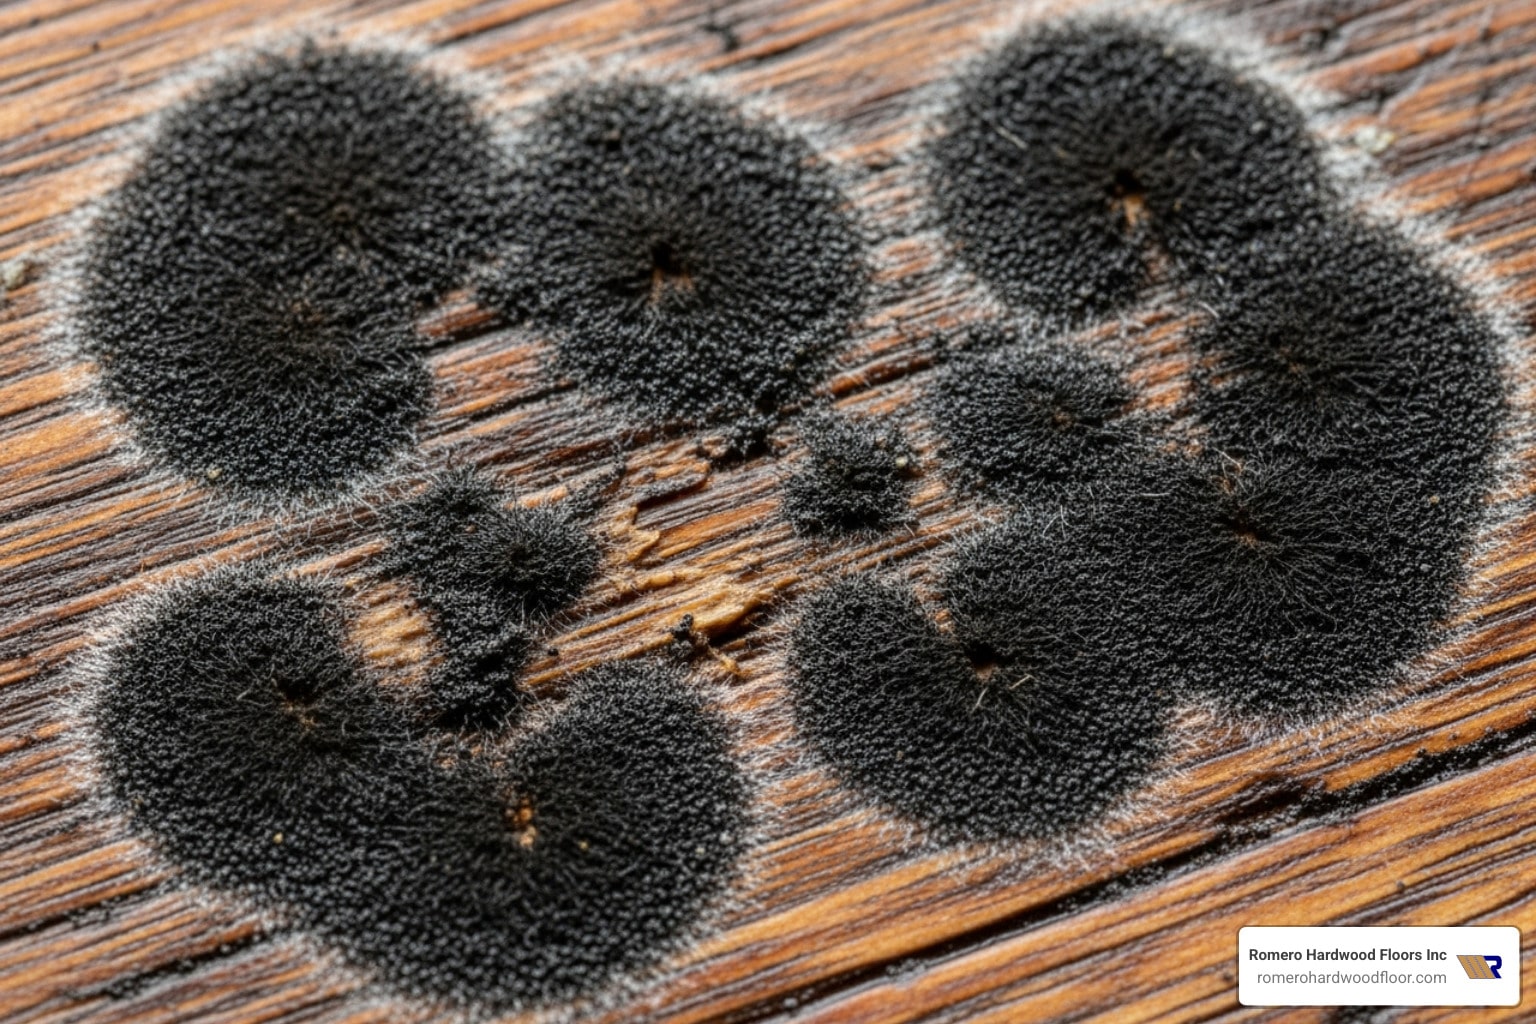
Hardwood Hero: Cleaning Mold from Your Floors

Black Mold on Hardwood Floors: Hero Guide 2025
The Hidden Threat Lurking Beneath Your Feet
Black mold on hardwood floors is more than just an unsightly problem – it’s a serious health hazard that can destroy your beautiful flooring investment. When moisture meets the organic material in wood, mold can begin growing in as little as 24-48 hours, often spreading undetected beneath the surface where you can’t see it.
Quick Answer: How to Remove Black Mold from Hardwood Floors
- Safety first – Wear N95 mask, gloves, and goggles
- Clean surface mold – Use white vinegar solution or hydrogen peroxide
- Sand deep stains – Start with 100-grit, finish with 220-grit sandpaper
- Call professionals – For areas over 10 square feet or structural damage
- Fix moisture source – Address leaks, humidity, and ventilation issues
The research shows that mold doesn’t need severe water damage to take hold. Something as simple as overwatering your plants can cause water to spill onto your floorboards and create the perfect environment for mold growth underneath. Mold thrives in damp, humid environments, and once it takes root on wood surfaces, it can lead to decay, weakening the wood’s structure over time.
As Francisco Romero, owner of Romero Hardwood Floors Inc. with over 15 years of experience in Revere, MA, I’ve seen how black mold on hardwood floors can devastate beautiful installations when not addressed quickly. My team and I have helped countless homeowners restore their floors and implement prevention strategies to protect their investment for years to come.

Common black mold on hardwood floors vocab:
Understanding Mold on Your Hardwood Floors
Your beautiful hardwood floors might look pristine on the surface, but there’s a hidden enemy that could be lurking beneath – one that doesn’t need much invitation to move in and make itself at home. Mold spores are literally everywhere, floating invisibly in the air around us right now. Most of the time, they’re completely harmless. But when these microscopic hitchhikers land on damp wood? That’s when your flooring nightmare begins.
Moisture, organic material, and time – these three simple ingredients are all mold needs to transform from harmless spores into a serious problem. Your hardwood floors, being made of organic wood fibers, provide the perfect feast. Add a little water from a leak, spill, or high humidity, and you’ve essentially rolled out the red carpet for mold growth.
Here’s what makes this particularly tricky: black mold on hardwood floors often starts its invasion completely out of sight. It might be growing happily under your floorboards, behind baseboards, or in microscopic cracks in the wood while you’re none the wiser. By the time you notice that musty smell or see visible signs, the mold colony has likely been establishing itself for days or even weeks.
Understanding the early warning signs and what creates the perfect storm for mold growth is your first line of defense. For a deeper dive into these issues, explore our specialized Hardwood Floor Water Damage Repair services.
What Causes Mold to Grow on Wood?
The scary truth? Mold can start growing on wet wood in as little as 24-48 hours. Your hardwood floors normally maintain a moisture content of around 10% or less – that’s their happy, healthy state. But once moisture levels climb to 18% or higher, you’re in the danger zone where mold feels right at home.
Water leaks are the biggest troublemakers. That slow drip from under your kitchen sink, a tiny roof leak that only shows up during heavy rain, or even your refrigerator’s ice maker acting up – these seemingly minor issues can create major mold problems. We’ve seen homeowners find extensive black mold on hardwood floors that started from something as simple as a dishwasher connection that was slightly loose.
High humidity is another silent culprit. When indoor humidity consistently stays above 50-60%, your wood floors act like sponges, slowly absorbing that excess moisture from the air. Think of it like a really slow-motion flood – the end result can be just as devastating. The ideal humidity range for your home is 30-50%, which keeps your floors happy and mold-free.
Condensation loves to form when warm, moist air meets cooler surfaces. This happens a lot in basements, under area rugs, or anywhere there’s a significant temperature difference. Poor ventilation makes everything worse by trapping that moist air and creating stagnant pockets where mold can flourish undisturbed.
Don’t underestimate everyday spills and accidents either. Overwatering your houseplants, pet water bowls that overflow, or even that glass of wine you knocked over last week – if moisture sits on wood long enough, it’s an open invitation for mold. For detailed guidance on addressing water damage quickly, visit our resource on Fix Wood Floor Water Damage.
The key takeaway? Time is absolutely critical. The faster you can eliminate moisture and dry out affected areas, the better your chances of preventing mold from taking hold.
Common Signs of a Mold Problem
Mold is sneaky – it often prefers to party in places where you can’t see it. Under floorboards, behind furniture, in dark corners – these hidden growth areas mean you need to become a detective, looking for clues that point to a mold problem brewing beneath the surface.
Your nose knows first. That distinctive musty odor – think damp basement or old gym socks – is often your earliest warning sign. If you walk into a room and catch that earthy, unpleasant smell, trust your instincts. Mold can start producing that telltale odor within just a week of beginning to grow.
Discoloration comes in many forms, and black mold on hardwood floors is just one possibility. You might see black, green, white, brown, or even orange spots appearing on your wood. Sometimes it looks fuzzy, other times slimy or powdery. Don’t assume it’s just dirt – if it doesn’t wipe away easily and keeps coming back, you’re likely dealing with mold.

Warping and cupping happen when moisture causes your wood to swell unevenly. Warping makes floorboards pull away from the subfloor, while cupping causes the edges of planks to rise, creating a wavy appearance. If your once-flat floor now looks like it’s doing the wave, moisture damage is likely the cause.
Watch for peeling finish where the protective coating on your floors starts to bubble, crack, or peel away. This often indicates moisture trapped underneath – exactly where mold loves to grow. A spongy texture when you walk across certain areas is even more concerning, as it suggests the wood’s structure is actually weakening from prolonged moisture exposure.
Here’s a surprising one: insect infestations. Bugs like carpenter ants and termites are attracted to damp, deteriorating wood. If you’re suddenly seeing more creepy crawlers than usual, they might be leading you to a moisture problem that’s also supporting mold growth.
If you’re noticing warping or lifting issues, our Hardwood Floor Lifting Repair services can help assess the extent of the damage and determine the best course of action.
Identifying Black Mold on Hardwood Floors vs. Other Growths
When most people worry about black mold on hardwood floors, they’re thinking of Stachybotrys chartarum – the infamous “toxic black mold” that gets all the scary headlines. This particular variety is indeed black or greenish-black and often has a slimy appearance. It’s gained notoriety because it can produce mycotoxins, which are potentially harmful compounds.
But here’s what might surprise you: not all black-colored mold is the “toxic” kind. Common molds like Alternaria and Cladosporium can also appear black or dark green. Meanwhile, other mold species show up in completely different colors – Penicillium and Aspergillus often appear white, blue-green, or gray.
The truth is, all mold growth should be taken seriously, regardless of color. Even “non-toxic” molds are considered allergenic, meaning they can trigger allergic reactions, respiratory issues, and other health problems in sensitive individuals.
So how do you tell if you’re dealing with mold versus just regular dirt or mildew? Dirt is usually dry and dusty – it sweeps or wipes away easily and doesn’t have any smell. Mildew typically appears as a flat, powdery growth in white, gray, or yellow, and it’s usually a surface problem that’s relatively easy to clean.
Mold, on the other hand, can be fuzzy, slimy, or powdery, comes in various colors, and almost always has that distinctive musty smell. More importantly, mold can actually penetrate into the wood fibers, making it much harder to eliminate completely.
For definitive identification, especially if you suspect you’re dealing with Stachybotrys chartarum or have extensive growth, professional testing is your best bet. Lab analysis can determine exactly what species you’re dealing with, which helps determine the most effective removal strategy and safety precautions needed.
Health Risks of Black Mold on Hardwood Floors
The health risks from black mold on hardwood floors extend far beyond just damaging your beautiful flooring – they can seriously impact you and your family’s wellbeing. When mold grows, it releases tiny spores into the air that are invisible to the naked eye but can cause very visible health problems when inhaled.
Respiratory issues are the most common complaints we hear from homeowners dealing with mold problems. Coughing, wheezing, shortness of breath, and nasal irritation can all result from breathing in mold spores. For people who already have asthma, mold exposure can trigger severe asthma attacks that may require emergency medical attention.
Allergic reactions affect many people exposed to mold, even if they’ve never had mold allergies before. Sneezing, runny nose, red and itchy eyes, skin rashes, and throat irritation are all common symptoms. Some people find they’re sensitive to mold only after prolonged exposure in their own homes.
More concerning are the systemic effects that can develop with longer exposure, particularly to toxigenic molds like Stachybotrys chartarum. Persistent headaches, chronic fatigue, and nausea can significantly impact your quality of life and are often misdiagnosed because people don’t immediately connect these symptoms to their home environment.
Vulnerable individuals face the greatest risks. Small children, elderly family members, and anyone with compromised immune systems or pre-existing respiratory conditions can experience more severe and persistent symptoms. For these groups, mold exposure isn’t just uncomfortable – it can be genuinely dangerous.
Here’s something crucial to remember: mold spores become more airborne during cleaning and removal, which means the health risks can actually increase temporarily during remediation. This is why proper protective equipment and ventilation aren’t optional – they’re essential for protecting your health while you protect your floors.
Your Step-by-Step Guide to Removing Black Mold on Hardwood Floors
Finding black mold on hardwood floors can feel overwhelming, but here’s some good news: if you’re dealing with a smaller area (under 10 square feet), you can often tackle it yourself! The EPA considers these smaller outbreaks perfect for DIY mold removal. However, safety comes first, and it’s crucial to understand when you’re in over your head.
I’ve walked countless homeowners through this process over my 15+ years in the business. The key is being methodical, patient, and never cutting corners on safety. Think of it like a three-step dance: prepare properly, clean thoroughly, and address deep damage when needed.
Now, let’s walk through each step together.
Step 1: Safety and Preparation
Before you even think about touching that mold, we need to talk safety. Mold spores are sneaky little troublemakers that love to become airborne the moment you disturb them. I’ve seen too many well-intentioned homeowners skip this step and end up with respiratory issues or spread mold to other rooms.
Your personal protective equipment is non-negotiable. You’ll need an N95 mask – not just any dust mask, but a proper N95 mask designed to filter out tiny particles like mold spores. Rubber gloves will protect your skin from both mold and cleaning solutions, while safety goggles keep spores and chemicals away from your eyes.

Ventilation is your best friend during this process. Open windows and doors to create airflow, and if possible, use fans to blow air out of the room rather than just circulating it around. If it’s a humid day outside, run a dehumidifier inside instead – we don’t want to add more moisture to the mix!
For larger mold problems, isolate the affected room by closing doors and sealing vents with plastic sheeting and painter’s tape. This prevents spores from hitchhiking to other parts of your home. Clear out furniture, rugs, and other items to give yourself plenty of workspace and avoid cross-contamination.
Step 2: Cleaning Surface Mold
Now comes the satisfying part – actually getting rid of that mold! For surface mold that hasn’t burrowed deep into your wood, these cleaning methods work like magic. The key is choosing the right solution and being thorough without oversaturating your floors.
White vinegar solution is my go-to recommendation for most homeowners. White vinegar is natural, wood-safe, and actually penetrates porous surfaces to kill mold at its roots. Mix equal parts white vinegar and water in a spray bottle, then spray the moldy area without soaking the wood. Let it sit for about an hour – this gives the vinegar time to do its work. Gently scrub with a soft brush, wipe clean with a damp cloth, then dry thoroughly.
Hydrogen peroxide offers another excellent alternative to harsh bleach. Mix one part 3% hydrogen peroxide with two parts water, apply it to the affected area, and let it sit for about 10 minutes. After a gentle scrub, wipe clean and dry completely. It’s effective at killing mold while being gentler on your floors.
For stubborn stains, try a baking soda paste made from baking soda and a small amount of water. This natural deodorizer and mild abrasive can help lift mold stains when you let it sit for a few minutes before gently scrubbing.
Commercial mold cleaners designed specifically for wood can also be effective. Products like Concrobium Mold Control are popular because they work without harsh chemicals. Always follow the manufacturer’s instructions and choose products safe for hardwood.
Important safety note: Never mix cleaning products! Combining bleach with ammonia or acids like vinegar creates dangerous, toxic gases. For more general cleaning guidance, check our comprehensive guide on What is Best to Clean Hardwood Floors.
Step 3: Addressing Ingrained Mold and Stains
Sometimes mold is stubborn and penetrates deeper into the wood grain, leaving stains that surface cleaning can’t touch. Don’t worry – this doesn’t mean your floors are doomed! It just means we need to get a bit more aggressive with our approach.
Sanding the affected area becomes necessary when mold has truly stained or penetrated the wood. Start with 100-grit sandpaper to remove the top layer of affected wood, then follow up with 220-grit sandpaper to smooth the surface and prepare it for refinishing. Take your time here – patience pays off with better results.
Some experts suggest periodically spraying a dilute bleach solution while sanding to prevent mold spores from becoming airborne. However, use extreme caution since bleach can damage wood if used improperly. I typically recommend focusing on thorough dust removal and proper ventilation instead.
After sanding, use a HEPA vacuum to remove all sawdust and lingering mold spores. Regular vacuums might miss these tiny particles, but HEPA (High-Efficiency Particulate Air) filters are designed specifically to capture them.
Refinishing the sanded area protects the wood and helps match the rest of your floor. This involves applying a protective coating like polyurethane once the area is completely clean and dry. For seamless results, especially in highly visible areas, consider professional Hardwood Floor Refinishing for the entire room.
If you’re dealing with a smaller spot, you might attempt to blend it yourself. Our expertise in Hardwood Floor Scratch Repair often involves similar refinishing techniques that could help guide your approach.
Remember: patience is crucial here. Ensure the wood is completely dry before applying any new finish. This step not only restores your floor’s appearance but also seals it against future moisture problems.
When to Call a Professional for Mold Remediation
While tackling black mold on hardwood floors yourself might seem like a money-saving hero move, there are definitely times when calling in the professionals is the smarter choice. Think of it this way: you wouldn’t perform surgery on yourself, right? Some mold situations require that same level of expertise and specialized equipment.
The EPA recommends professional help for any mold infestation covering more than 10 square feet. That’s roughly the size of a small bathroom, and trust me, mold doesn’t respect boundaries – it loves to spread! But size isn’t the only factor to consider.
Hidden mold is another major red flag. You know that persistent musty smell that just won’t go away, even after you’ve cleaned everything visible? That’s often mold partying under your floorboards, behind walls, or in other sneaky spots where your cleaning supplies can’t reach. Professionals have moisture meters, infrared cameras, and other detective tools to track down these hidden culprits.
If your floors show structural damage – extensive warping, cupping, or that spongy feeling when you walk – you’re looking at more than just a surface cleaning job. This kind of damage often means the mold has been having a field day for quite some time, potentially affecting the subfloor and requiring specialized repair techniques.
Recurring mold is like that annoying relative who keeps showing up uninvited – it means you haven’t addressed the root cause. Professional services don’t just clean what’s visible; they identify and fix the moisture sources that keep feeding the problem.
Most importantly, if anyone in your household is experiencing persistent respiratory issues, allergies, or other health problems that started around the same time as your mold findy, don’t mess around. Call the pros immediately. Your family’s health is worth more than any DIY savings.
For any significant damage or if you’re unsure about the extent of the problem, our team at Romero Hardwood Floors Inc. can help assess the situation and provide expert guidance on Hardwood Floor Repair.
| Criteria | DIY Mold Removal | Professional Mold Remediation |
|---|---|---|
| Cost | $50-200 for supplies | $1,100-9,000+ depending on severity |
| Time | 1-2 days for small areas | 3-7 days including drying time |
| Safety | Higher risk of exposure | Professional containment and safety protocols |
| Effectiveness | Good for surface mold under 10 sq ft | Comprehensive removal including hidden mold |
Note: Professional costs are national averages from online data, not quotes from Romero Hardwood Floors, and can vary significantly based on the extent of damage and location.
Signs Your Hardwood Floor is Beyond Repair
Nobody wants to hear that their beautiful hardwood floors are beyond saving, but sometimes being realistic can save you from throwing good money after bad. It’s like that old car that keeps breaking down – at some point, you’ve got to know when to say goodbye.
Extensive warping or cupping across large areas is usually a death sentence for hardwood floors. While a few boards here and there can sometimes be replaced, when your entire floor looks like a wooden roller coaster, the structural integrity is shot. The wood fibers have been so damaged by moisture that they’ll never lay flat again.
Widespread rot is another clear indicator. If the wood has that soft, spongy feel or you can actually poke a screwdriver into it without much effort, the cellulose structure has broken down. At this point, you’re not dealing with flooring anymore – you’re dealing with wood pulp held together by hope and habit.
Subfloor damage is particularly serious because it affects the foundation of your entire flooring system. If moisture has seeped through to rot or mold the subfloor, you’re looking at a complete tear-out and replacement job. There’s simply no way to properly restore flooring over a compromised base.
The persistent musty smell after cleaning is like a ghost that won’t be exorcised – it means there’s hidden mold growth that cleaning can’t reach. This often indicates the mold has penetrated so deeply into the wood structure that surface treatments are useless.
When facing these situations, attempting restoration is often like putting a band-aid on a broken bone. It’s safer and more cost-effective to remove the damaged materials completely and start fresh. Our team can guide you through the process of Restoring Old Floors or advise on new installations when restoration isn’t viable.
What to Expect from a Professional Service
When you call in professional mold remediation specialists, you’re getting a lot more than just a cleaning crew with fancy equipment. These folks are like the Navy SEALs of the cleaning world – they come prepared for battle and know exactly how to win the war against mold.
The process typically starts with a thorough inspection and assessment. Professionals use moisture meters, infrared cameras, and air quality testing to map out exactly what they’re dealing with. They’re not just looking at what you can see – they’re hunting down every hidden pocket of mold like detectives solving a case.
Containment comes next, and this is where you really see the difference between DIY and professional work. They’ll seal off the affected area with heavy plastic sheeting and create negative air pressure to prevent spores from escaping to other parts of your home. It’s like creating a bubble around the problem.
Air filtration systems with HEPA filters run continuously during the process, capturing airborne spores that get disturbed during removal. These aren’t your average shop vacuums – they’re industrial-grade machines that can filter particles down to 0.3 microns.
The actual mold removal involves specialized techniques and commercial-grade products that aren’t available to consumers. Professionals know which products work best on different types of mold and how to apply them safely without damaging your floors or creating toxic fumes.
Drying and dehumidification follow, using commercial dehumidifiers and air movers to ensure the area is completely dry. This step is crucial because any remaining moisture is just an invitation for mold to return.
Finally, repair and restoration bring your floors back to their former glory. This might involve replacing damaged boards, refinishing, or even complete reinstallation depending on the extent of damage.
The average cost for professional mold remediation ranges from $1,100 to over $9,000, depending on the severity and extent of the problem. These are national averages from online data, not quotes from our services, and costs can vary significantly based on your specific situation and location.
For comprehensive restoration services, check out our Hardwood Restoration Services to see how we can help bring your floors back to life.